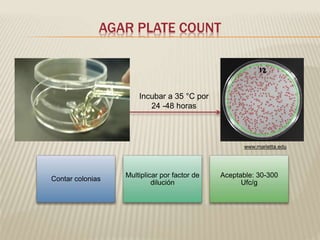
AGAR PLATE COUNT 
Incubar a 35 °C por 
24 -48 horas 
Contar colonias 
Multiplicar por factor de 
dilución 
www.marietta.edu 
Aceptable: 30-300 
Ufc/g
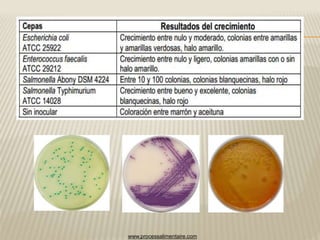
www.processalimentaire.com
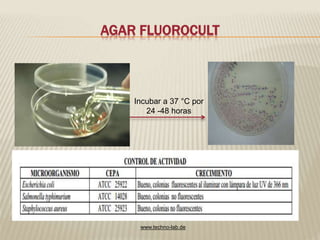
AGAR FLUOROCULT 
Incubar a 37 °C por 
24 -48 horas 
www.techno-lab.de

1) El documento describe varios medios de cultivo usados en microbiología como el agar EMB, agar Sabouraud, agar MacConkey y agar cetrimide para el aislamiento de diferentes microorganismos. 2) También presenta información sobre métodos como el recuento de placas para determinar la contaminación bacteriana de alimentos y el uso de caldos y agar para pruebas de sensibilidad a antibióticos. 3) Finalmente, menciona otros reactivos como la prueba de oxidasa para la identificación bacteriana.